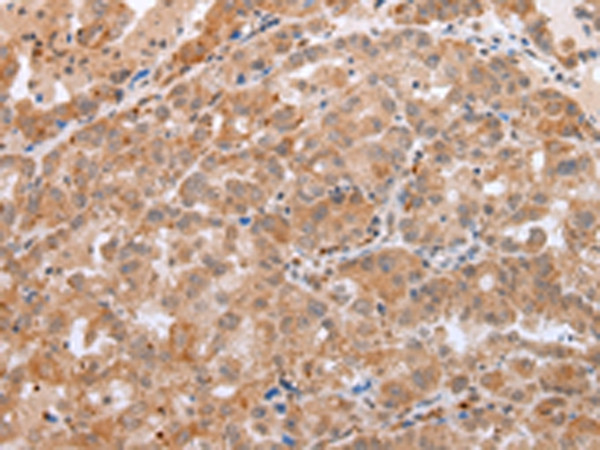
beta-Defensin 1 Antibody in Immunohistochemistry (Paraffin) (IHC (P))

Search
Invitrogen
beta-Defensin 1 Polyclonal Antibody
{{$productOrderCtrl.translations['antibody.pdp.commerceCard.promotion.promotions']}}
{{$productOrderCtrl.translations['antibody.pdp.commerceCard.promotion.viewpromo']}}
{{$productOrderCtrl.translations['antibody.pdp.commerceCard.promotion.promocode']}}: {{promo.promoCode}} {{promo.promoTitle}} {{promo.promoDescription}}. {{$productOrderCtrl.translations['antibody.pdp.commerceCard.promotion.learnmore']}}

Please note: We are reviewing Western blot images included in the antibody testing data in our catalog, including those provided by third parties. Unless expressly labeled or annotated as “raw-unedited”, Western blot images included in the antibody testing data in our catalog may have been edited, optimized or otherwise adjusted for presentation.
产品信息
PA5-51286
种属反应
已发表种属
宿主/亚型
分类
类型
抗原
偶联物
形式
浓度
规格
纯化类型
保存液
内含物
保存条件
运输条件
RRID
产品详细信息
The antibody detects endogenous levels of total DEFB1 protein.
靶标信息
Defensins form a family of microbicidal and cytotoxic peptides made by neutrophils. Members of the defensin family are highly similar in protein sequence. This gene encodes defensin, beta 1, an antimicrobial peptide implicated in the resistance of epithelial surfaces to microbial colonization. This gene maps in close proximity to defensin family member, defensin, alpha 1 and has been implicated in the pathogenesis of cystic fibrosis.
仅用于科研。不用于诊断过程。未经明确授权不得转售。